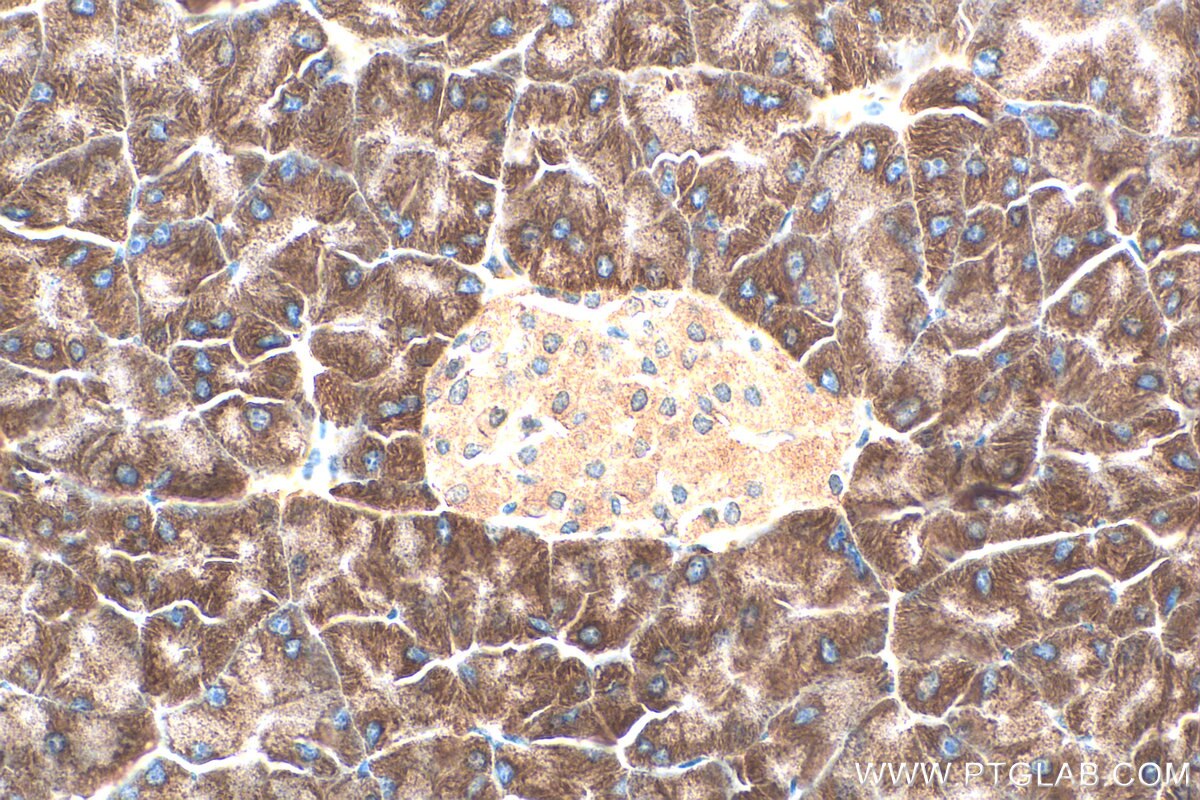
Immunohistochemistry (IHC) staining of mouse pancreas tissue using RPL28 Polyclonal antibody (16649-1-AP)
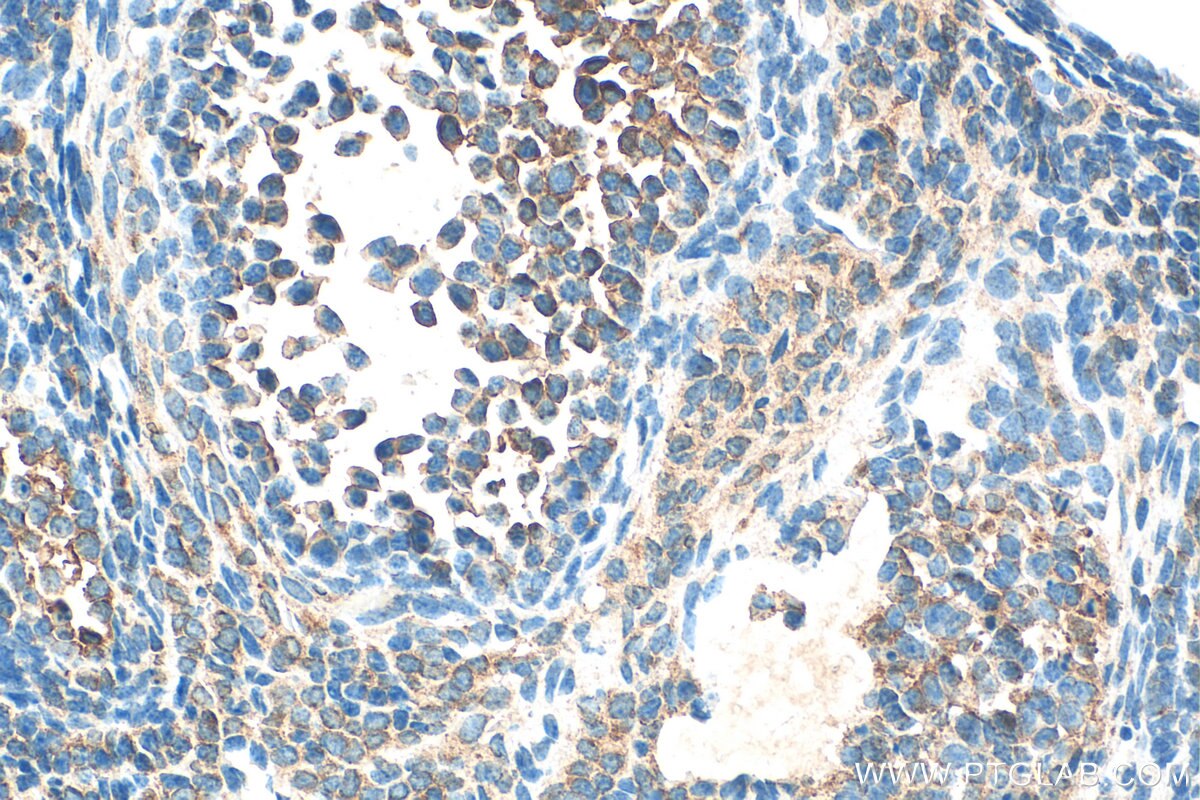
Immunohistochemistry (IHC) staining of mouse ovary tissue using RPL28 Polyclonal antibody (16649-1-AP)

Tested Applications
| Positive WB detected in | HeLa cells, NIH/3T3 cells |
Recommended dilution
| Application | Dilution |
|---|---|
| Western Blot (WB) | WB : 1:500-1:3000 |
| It is recommended that this reagent should be titrated in each testing system to obtain optimal results. | |
| Sample-dependent, Check data in validation data gallery. | |
Published Applications
| WB | See 7 publications below |
| IF | See 1 publications below |
| FC | See 1 publications below |
Product Information
16649-1-AP targets RPL28 in WB, IF, ELISA applications and shows reactivity with human, mouse, rat samples.
| Tested Reactivity | human, mouse, rat |
| Cited Reactivity | human, mouse |
| Host / Isotype | Rabbit / IgG |
| Class | Polyclonal |
| Type | Antibody |
| Immunogen |
CatNo: Ag10036 Product name: Recombinant human RPL28 protein Source: e coli.-derived, PGEX-4T Tag: GST Domain: 1-137 aa of BC010173 Sequence: MSAHLQWMVVRNCSSFLIKRNKQTYSTEPNNLKARNSFRYNGLIHRKTVGVEPAADGKGVVVVIKRRSGQRKPATSYVRTTINKNARATLSSIRHMIRKNKYRPDLRMAAIRRASAILRSQKPVMVKRKRTRPTKSS Predict reactive species |
| Full Name | ribosomal protein L28 |
| Calculated Molecular Weight | 137 aa, 16 kDa |
| Observed Molecular Weight | 16 kDa |
| GenBank Accession Number | BC010173 |
| Gene Symbol | RPL28 |
| Gene ID (NCBI) | 6158 |
| RRID | AB_2254021 |
| Conjugate | Unconjugated |
| Form | Liquid |
| Purification Method | Antigen affinity purification |
| UNIPROT ID | P46779 |
| Storage Buffer | PBS with 0.02% sodium azide and 50% glycerol, pH 7.3. |
| Storage Conditions | Store at -20°C. Stable for one year after shipment. Aliquoting is unnecessary for -20oC storage. 20ul sizes contain 0.1% BSA. |
Protocols
| Product Specific Protocols | |
|---|---|
| WB protocol for RPL28 antibody 16649-1-AP | Download protocol |
| Standard Protocols | |
|---|---|
| Click here to view our Standard Protocols |
Publications
| Species | Application | Title |
|---|---|---|
Genes Dev Uncoupling of GTP hydrolysis from eIF6 release on the ribosome causes Shwachman-Diamond syndrome. | ||
Transl Res Ribosomal proteins as distinct "passengers" of microvesicles: new semantics in myeloma and mesenchymal stem cells' communication. | ||
Aging Cell Inhibition of the 60S ribosome biogenesis GTPase LSG1 causes endoplasmic reticular disruption and cellular senescence. | ||
Elife Loss of Tsc1 in cerebellar Purkinje cells induces transcriptional and translation changes in FMRP target transcripts | ||
iScience Proteostasis regulated by testis-specific ribosomal protein RPL39L maintains mouse spermatogenesis. | ||
Sci Rep Germline variability and tumor expression level of ribosomal protein gene RPL28 are associated with survival of metastatic colorectal cancer patients. |